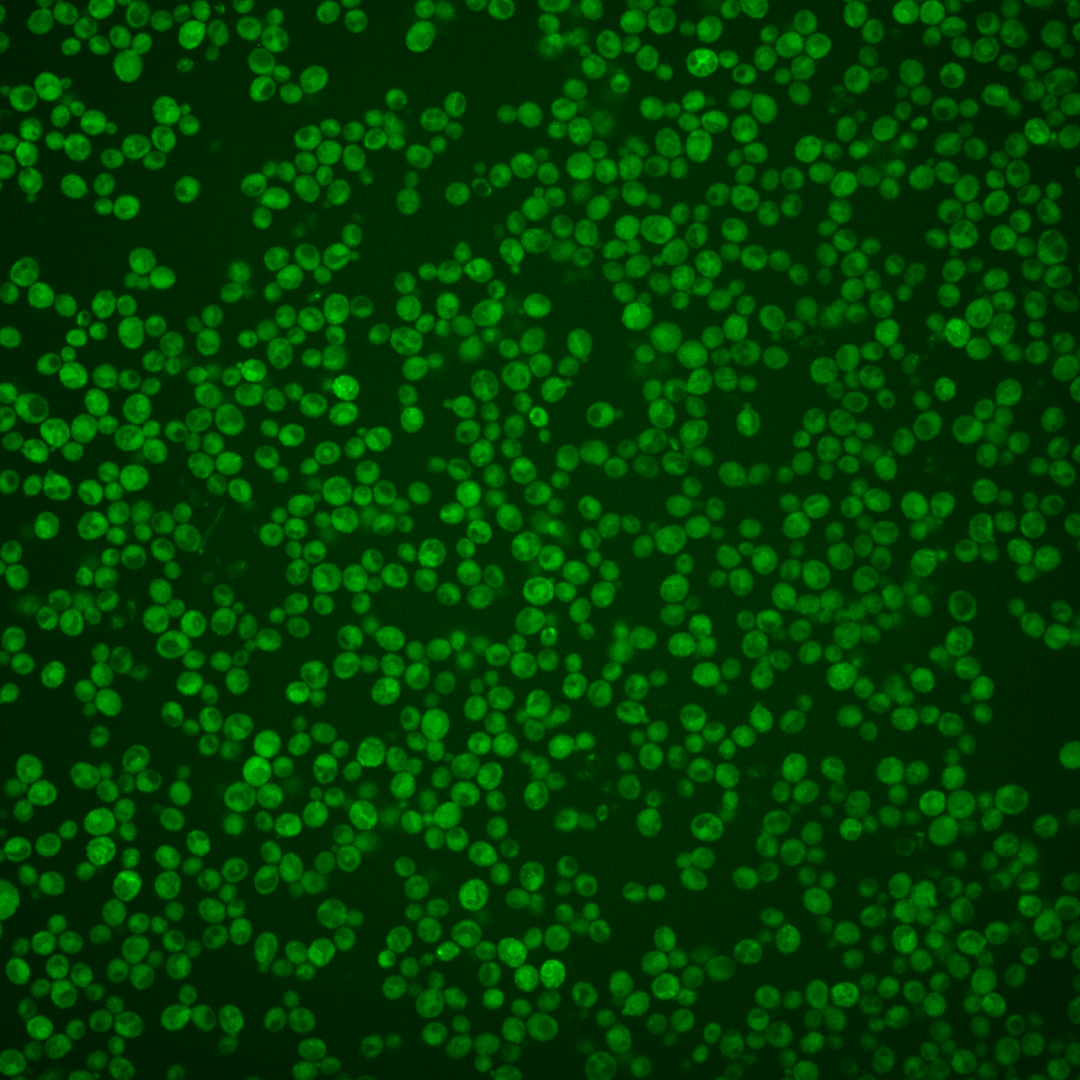
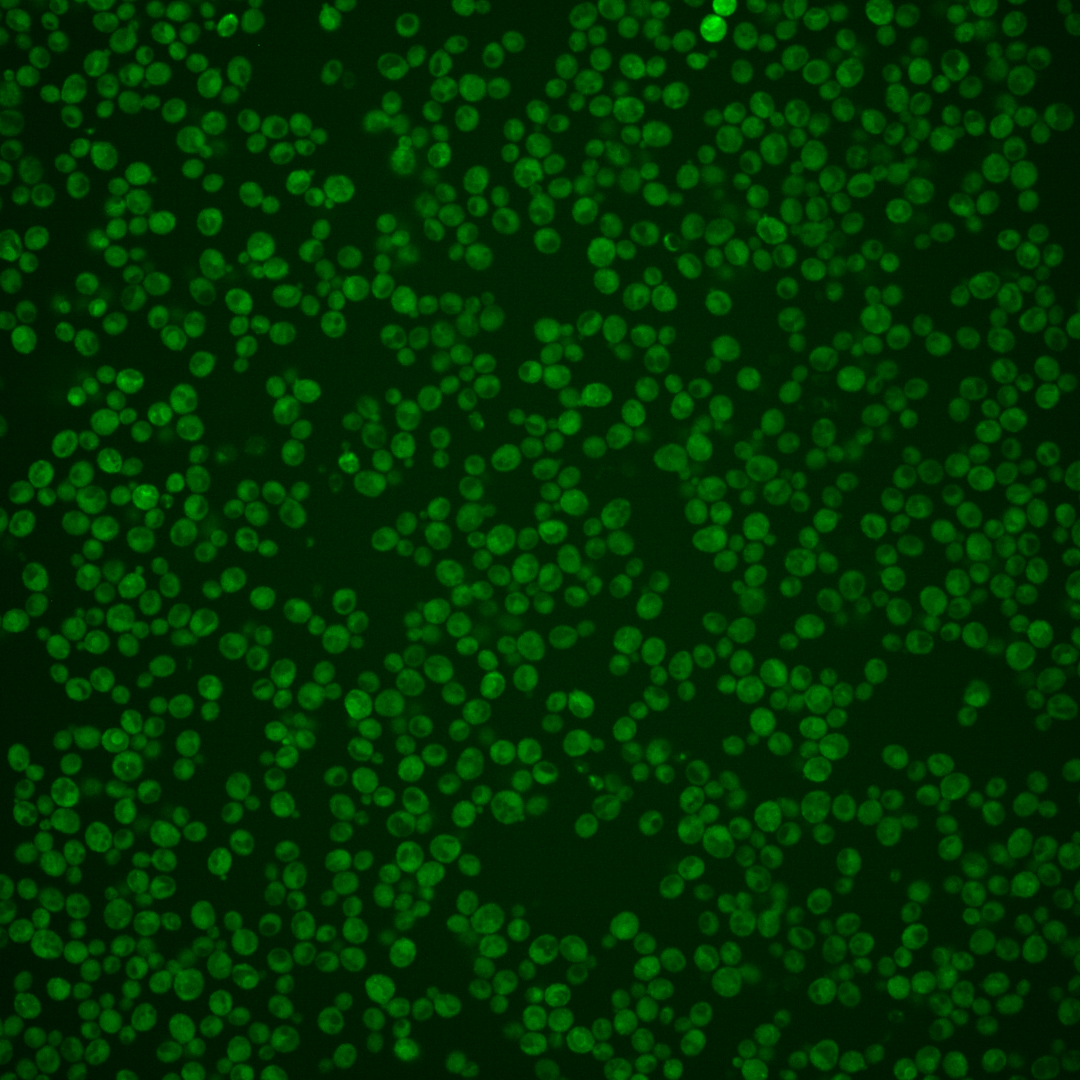
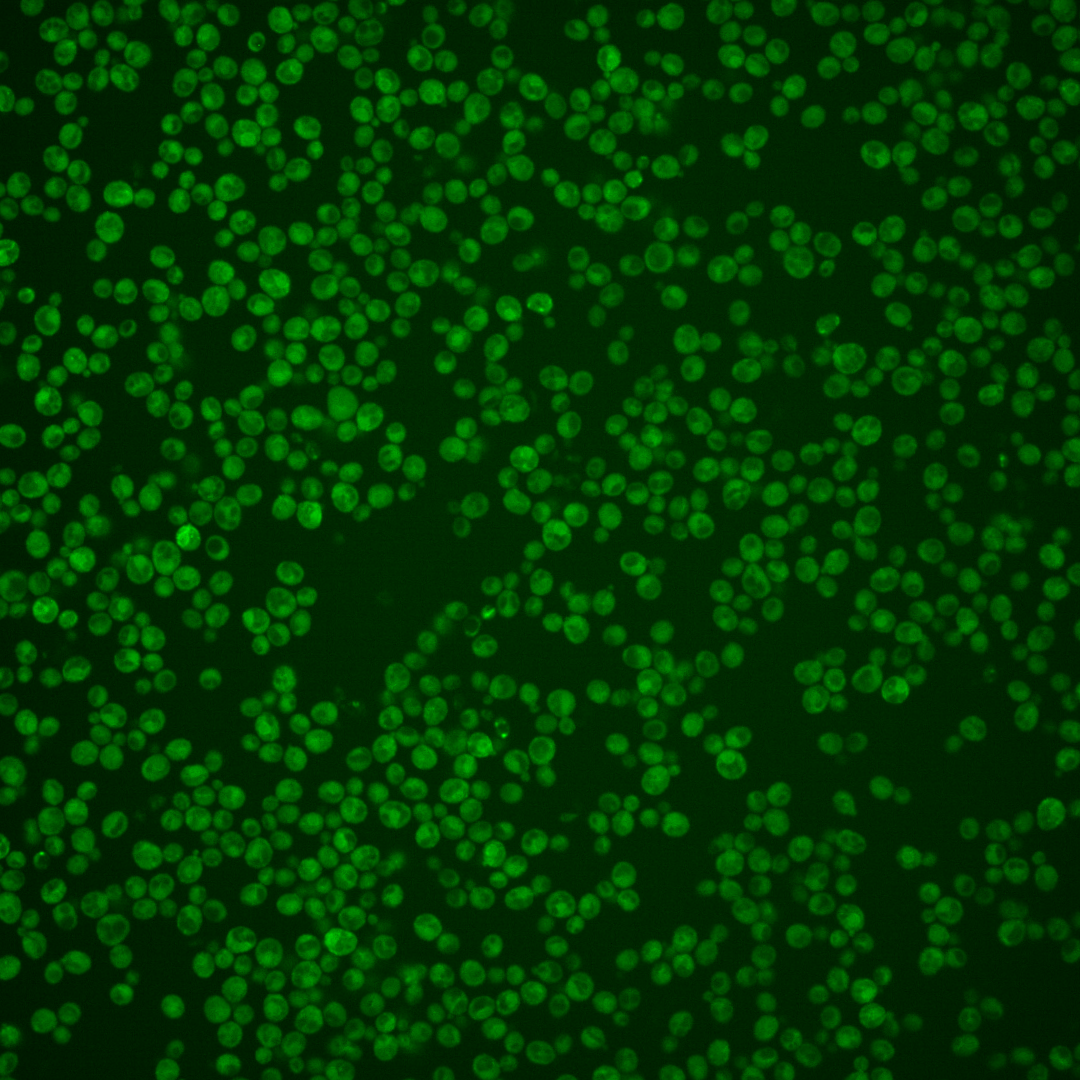
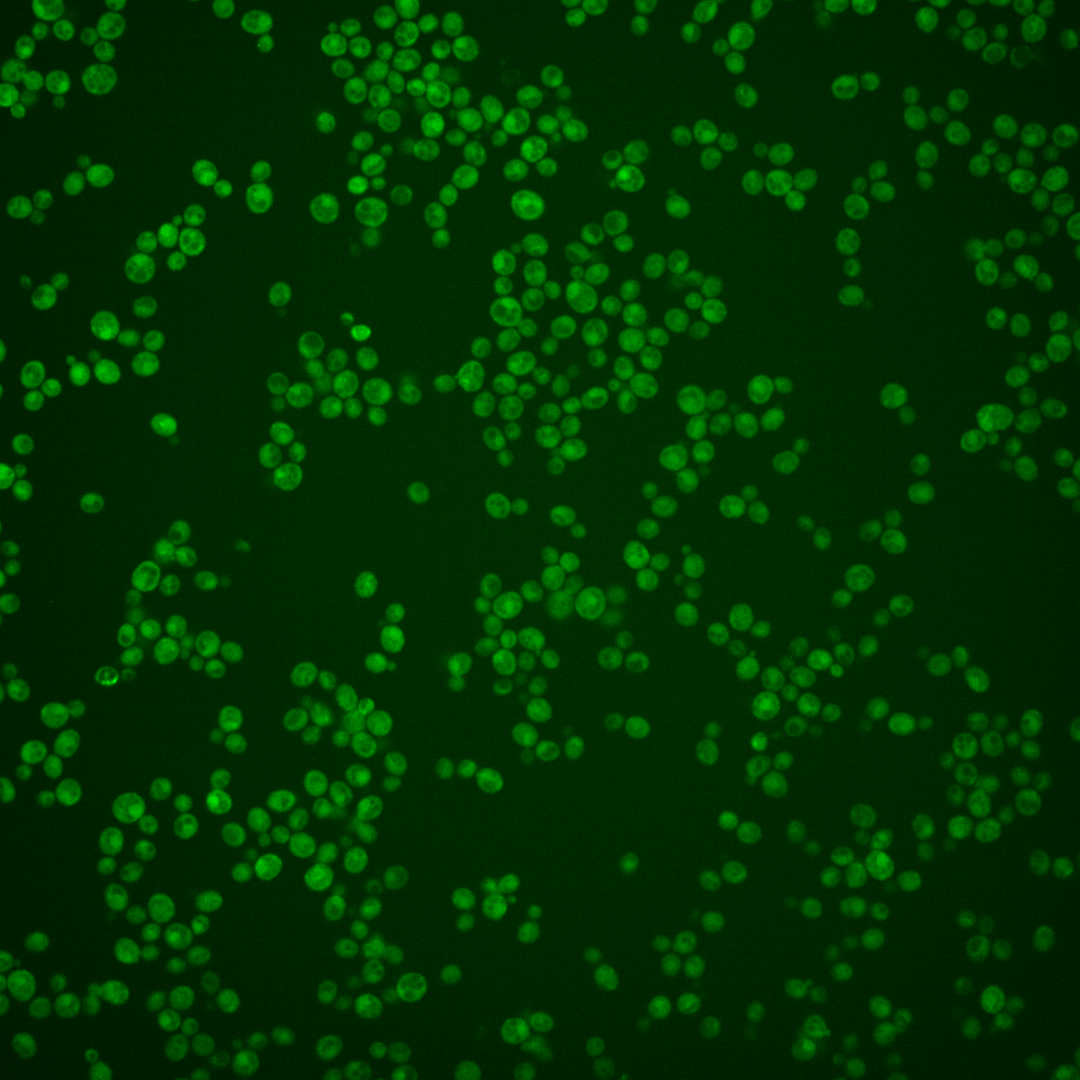
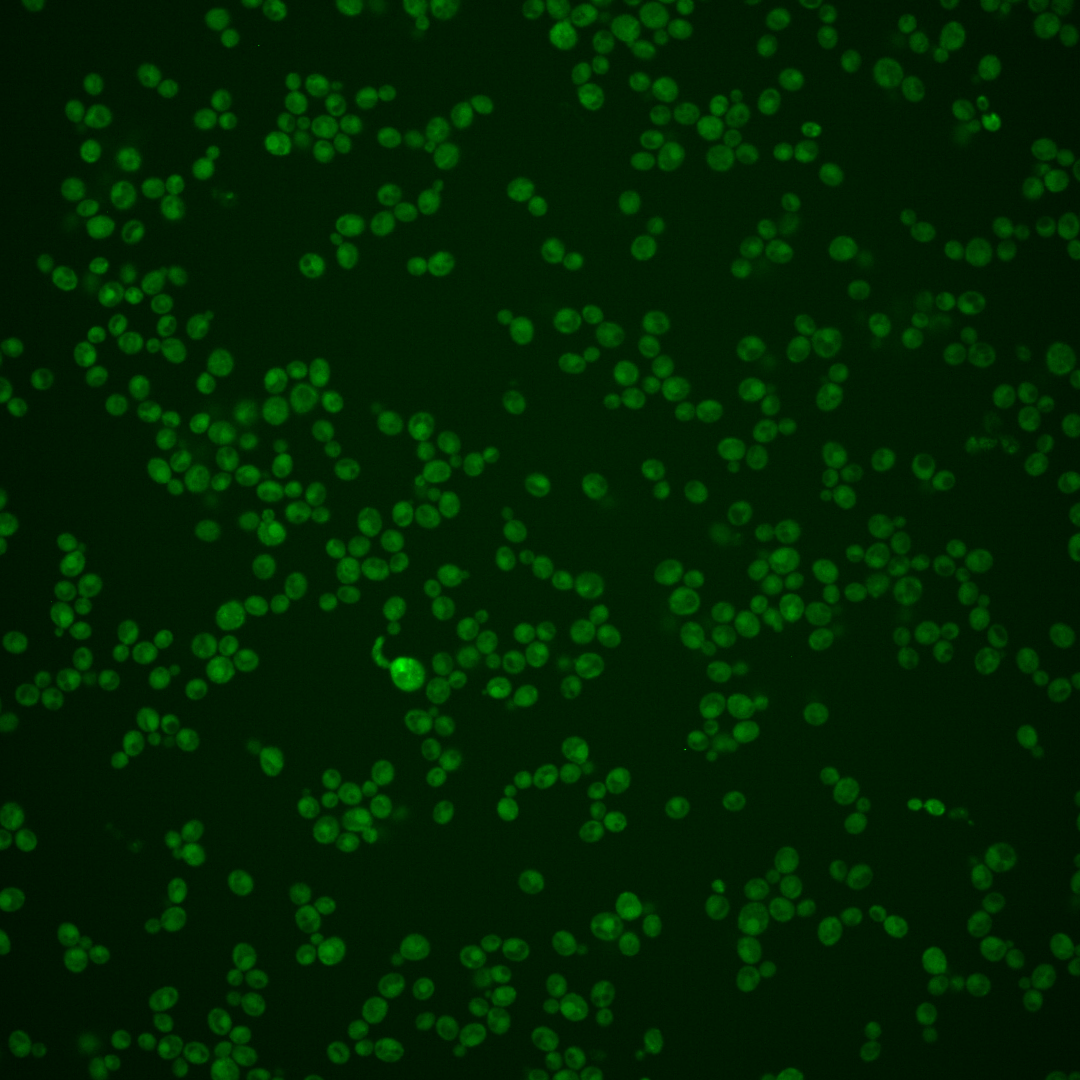
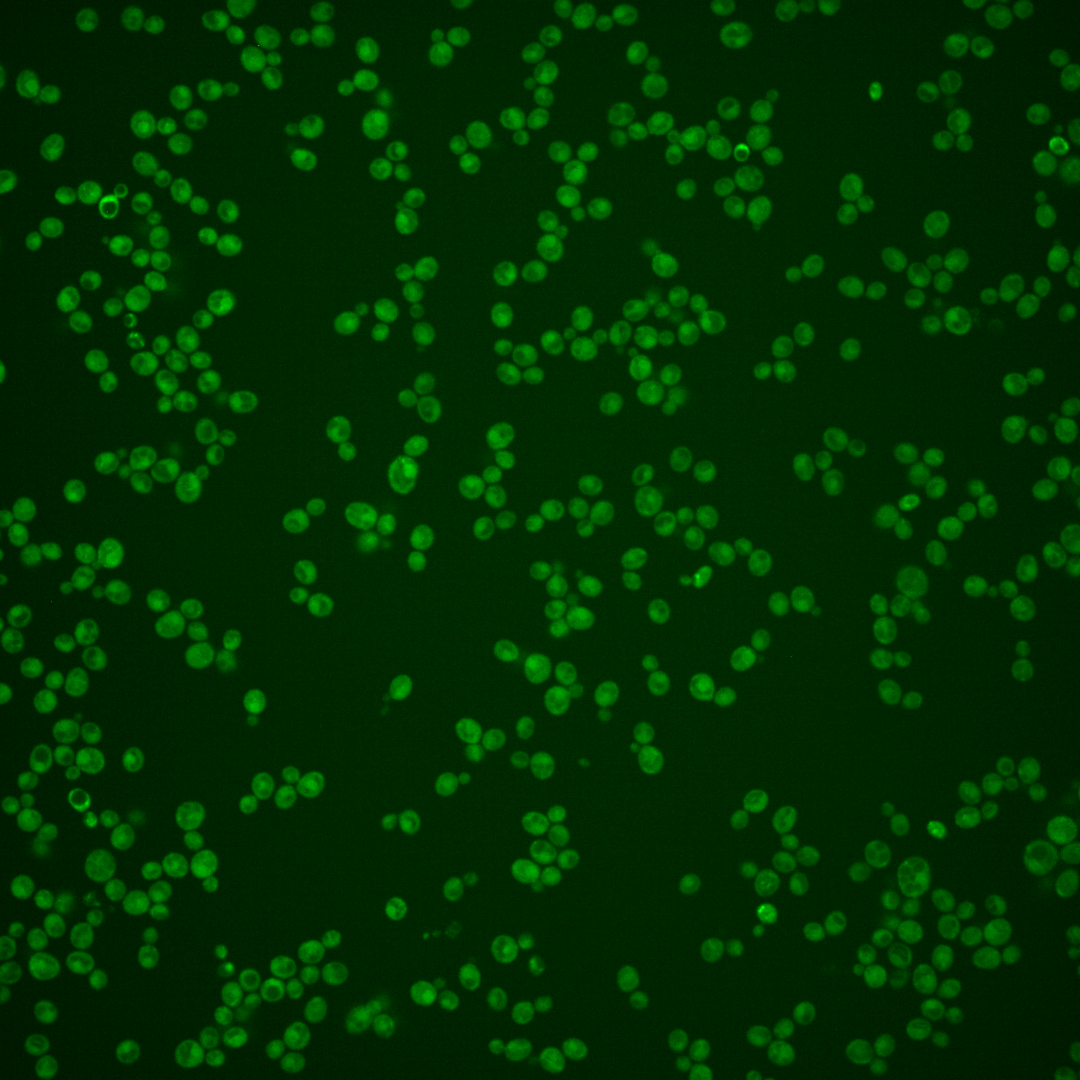

| Standard name | |
|---|---|
| Human Ortholog | |
| Description | Chitin transglycosylase; functions in the transfer of chitin to beta(1-6) and beta(1-3) glucans in the cell wall; similar and functionally redundant to Utr2; localizes to sites of polarized growth; expression induced by cell wall stress |
Micrographs




















































































Sub-cellular Localization
Yeast GFP Assignment
Protein Abundance
Localization Change
External localization resources
| ensLOC | DeepLoc | |||||||||||||||||||||||
|---|---|---|---|---|---|---|---|---|---|---|---|---|---|---|---|---|---|---|---|---|---|---|---|---|
| Localization | WT1 | WT2 | WT3 | RAP60 | RAP140 | RAP220 | RAP300 | RAP380 | RAP460 | RAP540 | RAP620 | RAP700 | HU80 | HU120 | HU160 | rpd3Δ_1 | rpd3Δ_2 | rpd3Δ_3 | WT1 | WT2 | WT3 | AF100 | AF140 | AF180 |
| Cortical Patches | 0 | 1 | 2 | 2 | 5 | 2 | 1 | 8 | 2 | 3 | 2 | 1 | 1 | 0 | 0 | 2 | 0 | 0 | 3 | 16 | 17 | 0 | 1 | 1 |
| Bud | 0 | 10 | 5 | 5 | 3 | 6 | 3 | 14 | 10 | 11 | 8 | 4 | 1 | 1 | 1 | 1 | 0 | 0 | 6 | 27 | 11 | 1 | 1 | 4 |
| Bud Neck | 0 | 0 | 0 | 0 | 0 | 0 | 0 | 0 | 0 | 0 | 0 | 0 | 0 | 0 | 0 | 0 | 0 | 0 | 3 | 14 | 5 | 0 | 3 | 2 |
| Bud Site | 0 | 0 | 0 | 0 | 0 | 0 | 0 | 0 | 0 | 0 | 1 | 0 | 0 | 0 | 0 | 0 | 0 | 0 | – | – | – | – | – | – |
| Cell Periphery | 0 | 8 | 4 | 5 | 11 | 28 | 9 | 11 | 5 | 8 | 2 | 10 | 6 | 7 | 3 | 11 | 7 | 14 | 1 | 3 | 2 | 1 | 2 | 0 |
| Cytoplasm | 111 | 235 | 153 | 93 | 101 | 205 | 244 | 341 | 195 | 276 | 140 | 150 | 123 | 205 | 234 | 120 | 50 | 44 | 51 | 114 | 57 | 54 | 106 | 80 |
| Endoplasmic Reticulum | 10 | 50 | 23 | 10 | 49 | 31 | 23 | 19 | 6 | 8 | 3 | 5 | 12 | 7 | 3 | 5 | 2 | 1 | 44 | 100 | 76 | 21 | 29 | 11 |
| Endosome | 0 | 1 | 1 | 2 | 0 | 0 | 1 | 5 | 0 | 1 | 0 | 0 | 0 | 0 | 0 | 3 | 0 | 2 | 3 | 7 | 4 | 0 | 0 | 1 |
| Golgi | 0 | 0 | 0 | 0 | 0 | 0 | 0 | 0 | 0 | 0 | 0 | 0 | 0 | 0 | 0 | 1 | 1 | 0 | 1 | 0 | 3 | 0 | 0 | 0 |
| Mitochondria | 4 | 2 | 5 | 1 | 0 | 4 | 9 | 11 | 9 | 15 | 8 | 20 | 3 | 0 | 2 | 1 | 0 | 1 | 3 | 11 | 11 | 0 | 2 | 4 |
| Nucleus | 0 | 0 | 0 | 0 | 0 | 0 | 1 | 1 | 2 | 0 | 1 | 0 | 1 | 0 | 0 | 0 | 0 | 1 | 0 | 0 | 0 | 0 | 1 | 0 |
| Nuclear Periphery | 1 | 1 | 0 | 1 | 0 | 1 | 0 | 0 | 0 | 0 | 1 | 0 | 0 | 0 | 0 | 0 | 0 | 0 | 0 | 1 | 1 | 0 | 0 | 0 |
| Nucleolus | 0 | 0 | 0 | 0 | 0 | 0 | 0 | 0 | 0 | 0 | 0 | 0 | 0 | 0 | 0 | 0 | 0 | 0 | 0 | 0 | 0 | 0 | 0 | 0 |
| Peroxisomes | 0 | 0 | 0 | 0 | 0 | 0 | 0 | 0 | 0 | 0 | 0 | 0 | 0 | 0 | 0 | 0 | 0 | 0 | 0 | 0 | 0 | 0 | 0 | 0 |
| SpindlePole | 0 | 0 | 0 | 0 | 0 | 0 | 0 | 0 | 0 | 0 | 0 | 0 | 0 | 0 | 1 | 0 | 0 | 0 | 0 | 1 | 0 | 0 | 0 | 0 |
| Vac/Vac Membrane | 0 | 2 | 5 | 2 | 2 | 4 | 20 | 14 | 8 | 13 | 9 | 12 | 0 | 0 | 1 | 7 | 5 | 3 | 10 | 19 | 9 | 2 | 7 | 10 |
| Unique Cell Count | 121 | 283 | 178 | 111 | 150 | 251 | 287 | 386 | 215 | 301 | 157 | 173 | 137 | 212 | 238 | 135 | 60 | 56 | 133 | 321 | 208 | 83 | 159 | 119 |
| Labelled Cell Count | 126 | 310 | 198 | 121 | 171 | 281 | 311 | 424 | 237 | 335 | 175 | 202 | 147 | 220 | 245 | 151 | 65 | 66 | 133 | 321 | 208 | 83 | 159 | 119 |
Yeast GFP Assignment
Protein Abundance
| Screen | WT1 | WT2 | WT3 | RAP60 | RAP140 | RAP220 | RAP300 | RAP380 | RAP460 | RAP540 | RAP620 | RAP700 | HU80 | HU120 | HU160 | rpd3Δ_1 | rpd3Δ_2 | rpd3Δ_3 | AF100 | AF140 | AF180 |
|---|---|---|---|---|---|---|---|---|---|---|---|---|---|---|---|---|---|---|---|---|---|
| Mean Cell GFP Intensity (1e-4) | 5.4 | 6.8 | 6.8 | 7.3 | 9.7 | 7.9 | 6.6 | 6.3 | 6.1 | 5.5 | 5.3 | 5.2 | 6.3 | 5.7 | 5.4 | 12.1 | 14.5 | 15.8 | 6.4 | 5.7 | 6.6 |
| Std Deviation (1e-4) | 1.3 | 1.8 | 2.4 | 2.4 | 2.8 | 2.5 | 2.1 | 1.8 | 1.7 | 1.7 | 1.5 | 1.8 | 1.7 | 1.4 | 1.6 | 5.4 | 6.4 | 7.2 | 3.7 | 1.6 | 2.3 |
| Intensity Change (Log2) | – | – | – | 0.11 | 0.52 | 0.22 | -0.03 | -0.11 | -0.16 | -0.31 | -0.36 | -0.4 | -0.12 | -0.24 | -0.33 | 0.84 | 1.09 | 1.22 | -0.07 | -0.24 | -0.04 |
Localization Change
| Localization | RAP60 | RAP140 | RAP220 | RAP300 | RAP380 | RAP460 | RAP540 | RAP620 | RAP700 | HU80 | HU120 | HU160 | rpd3Δ_1 | rpd3Δ_2 | rpd3Δ_3 |
|---|---|---|---|---|---|---|---|---|---|---|---|---|---|---|---|
| Cortical Patches | 0 | 0 | 0 | 0 | 0 | 0 | 0 | 0 | 0 | 0 | 0 | 0 | 0 | 0 | 0 |
| Bud | 0 | 0 | 0 | 0 | 0.5 | 0.9 | 0.5 | 1.1 | 0 | 0 | 0 | 0 | 0 | 0 | 0 |
| Bud Neck | 0 | 0 | 0 | 0 | 0 | 0 | 0 | 0 | 0 | 0 | 0 | 0 | 0 | 0 | 0 |
| Bud Site | 0 | 0 | 0 | 0 | 0 | 0 | 0 | 0 | 0 | 0 | 0 | 0 | 0 | 0 | 0 |
| Cell Periphery | 0 | 2.2 | 3.5 | 0 | 0 | 0 | 0 | 0 | 1.7 | 0 | 0.6 | 0 | 2.4 | 0 | 0 |
| Cytoplasm | -0.5 | -4.0 | -1.2 | -0.3 | 0.8 | 1.5 | 2.0 | 0.9 | 0.2 | 1.0 | 3.9 | 4.9 | 0.8 | -0.5 | -1.3 |
| Endoplasmic Reticulum | -1.0 | 4.3 | -0.2 | -1.7 | -3.4 | -3.8 | -4.4 | -3.8 | -3.5 | -1.2 | -3.6 | -4.9 | -2.8 | -2.1 | -2.4 |
| Endosome | 0 | 0 | 0 | 0 | 0 | 0 | 0 | 0 | 0 | 0 | 0 | 0 | 0 | 0 | 0 |
| Golgi | 0 | 0 | 0 | 0 | 0 | 0 | 0 | 0 | 0 | 0 | 0 | 0 | 0 | 0 | 0 |
| Mitochondria | 0 | 0 | 0 | 0.2 | 0 | 0.7 | 1.1 | 1.1 | 3.2 | 0 | 0 | 0 | 0 | 0 | 0 |
| Nucleus | 0 | 0 | 0 | 0 | 0 | 0 | 0 | 0 | 0 | 0 | 0 | 0 | 0 | 0 | 0 |
| Nuclear Periphery | 0 | 0 | 0 | 0 | 0 | 0 | 0 | 0 | 0 | 0 | 0 | 0 | 0 | 0 | 0 |
| Nucleolus | 0 | 0 | 0 | 0 | 0 | 0 | 0 | 0 | 0 | 0 | 0 | 0 | 0 | 0 | 0 |
| Peroxisomes | 0 | 0 | 0 | 0 | 0 | 0 | 0 | 0 | 0 | 0 | 0 | 0 | 0 | 0 | 0 |
| SpindlePole | 0 | 0 | 0 | 0 | 0 | 0 | 0 | 0 | 0 | 0 | 0 | 0 | 0 | 0 | 0 |
| Vacuole | 0 | 0 | 0 | 1.9 | 0.5 | 0.5 | 0.8 | 1.3 | 1.8 | 0 | 0 | 0 | 1.1 | 0 | 0 |
External localization resources
Images






























Protein Concentration and Protein Localization Data
| R1 | R2 | R3 | ||||||||||||||||
|---|---|---|---|---|---|---|---|---|---|---|---|---|---|---|---|---|---|---|
| G1 Pre-START | G1 Post-START | S/G2 | Metaphase | Anaphase | Telophase | G1 Pre-START | G1 Post-START | S/G2 | Metaphase | Anaphase | Telophase | G1 Pre-START | G1 Post-START | S/G2 | Metaphase | Anaphase | Telophase | |
| Concentration | 3.6779 | 6.9179 | 5.3516 | 4.9324 | 3.7468 | 5.8118 | 5.8935 | 9.1645 | 8.3014 | 7.0985 | 7.2198 | 8.2997 | 4.8152 | 4.7043 | 7.2907 | 5.6715 | 4.5277 | 8.2854 |
| Actin | 0.0445 | 0.0008 | 0.0131 | 0.0005 | 0.0234 | 0.0016 | 0.0273 | 0.0019 | 0.0296 | 0.0018 | 0.0376 | 0.0072 | 0.0018 | 0.0014 | 0.0054 | 0.0003 | 0.0095 | 0.0005 |
| Bud | 0.0006 | 0.0008 | 0.0006 | 0.0001 | 0.0006 | 0.0001 | 0.0011 | 0.002 | 0.0004 | 0.0008 | 0.0013 | 0.0012 | 0.0258 | 0.0093 | 0.0002 | 0.0001 | 0.0192 | 0 |
| Bud Neck | 0.0027 | 0.0005 | 0.0009 | 0.003 | 0.004 | 0.0096 | 0.0012 | 0.0008 | 0.0011 | 0.0007 | 0.0009 | 0.0117 | 0.0004 | 0.0007 | 0.0006 | 0.0006 | 0.002 | 0.0052 |
| Bud Periphery | 0.0035 | 0.0047 | 0.0008 | 0.0002 | 0.0008 | 0.0002 | 0.0024 | 0.0041 | 0.0008 | 0.0014 | 0.0109 | 0.0008 | 0.0106 | 0.0382 | 0.0001 | 0.0001 | 0.0112 | 0 |
| Bud Site | 0.0018 | 0.0034 | 0.0033 | 0.0002 | 0.0042 | 0.0001 | 0.0047 | 0.0058 | 0.0066 | 0.0015 | 0.0007 | 0.0003 | 0.0086 | 0.012 | 0.0014 | 0.0001 | 0.0026 | 0.0001 |
| Cell Periphery | 0.0102 | 0.0153 | 0.0034 | 0.0064 | 0.0014 | 0.001 | 0.004 | 0.0047 | 0.0036 | 0.0041 | 0.0061 | 0.0016 | 0.0039 | 0.0121 | 0.0009 | 0.0001 | 0.001 | 0.0006 |
| Cytoplasm | 0.3312 | 0.4641 | 0.5305 | 0.6604 | 0.6982 | 0.4845 | 0.3903 | 0.4548 | 0.5075 | 0.5172 | 0.5583 | 0.4702 | 0.4662 | 0.5143 | 0.4975 | 0.7236 | 0.6636 | 0.515 |
| Cytoplasmic Foci | 0.0238 | 0.0021 | 0.0133 | 0.0036 | 0.0275 | 0.0096 | 0.0408 | 0.0108 | 0.0106 | 0.0075 | 0.0095 | 0.0082 | 0.0153 | 0.0075 | 0.0275 | 0.0143 | 0.0211 | 0.0054 |
| Eisosomes | 0.0006 | 0.0001 | 0.0002 | 0 | 0.0002 | 0 | 0.0005 | 0 | 0.0002 | 0.0001 | 0.0005 | 0.0001 | 0.0003 | 0.0003 | 0 | 0 | 0.0001 | 0 |
| Endoplasmic Reticulum | 0.3893 | 0.3595 | 0.2958 | 0.2866 | 0.0358 | 0.4164 | 0.2979 | 0.4309 | 0.3349 | 0.3613 | 0.3128 | 0.4324 | 0.2158 | 0.1386 | 0.308 | 0.1656 | 0.1047 | 0.377 |
| Endosome | 0.0212 | 0.004 | 0.0315 | 0.0055 | 0.0678 | 0.0132 | 0.0618 | 0.026 | 0.0193 | 0.0331 | 0.0125 | 0.0168 | 0.0954 | 0.013 | 0.0367 | 0.0375 | 0.0486 | 0.029 |
| Golgi | 0.0049 | 0.0005 | 0.0036 | 0.0003 | 0.0021 | 0.0011 | 0.0224 | 0.0032 | 0.0051 | 0.0046 | 0.0032 | 0.0033 | 0.0048 | 0.002 | 0.0093 | 0.0026 | 0.033 | 0.0032 |
| Lipid Particles | 0.0167 | 0.0047 | 0.0105 | 0.0024 | 0.0081 | 0.0039 | 0.0287 | 0.0231 | 0.0125 | 0.0103 | 0.0064 | 0.0035 | 0.0085 | 0.004 | 0.0071 | 0.0016 | 0.0032 | 0.003 |
| Mitochondria | 0.0012 | 0.0001 | 0.0091 | 0.0001 | 0.0005 | 0.0002 | 0.0084 | 0.0008 | 0.0027 | 0.0015 | 0.0011 | 0.0076 | 0.0161 | 0.0157 | 0.0006 | 0.0002 | 0.0289 | 0.0001 |
| None | 0.0642 | 0.0636 | 0.0416 | 0.008 | 0.0391 | 0.0346 | 0.0679 | 0.0043 | 0.0388 | 0.0036 | 0.0107 | 0.0136 | 0.0785 | 0.1728 | 0.0584 | 0.0427 | 0.0114 | 0.0396 |
| Nuclear Periphery | 0.0121 | 0.0132 | 0.0165 | 0.0064 | 0.0253 | 0.0046 | 0.0096 | 0.0066 | 0.0057 | 0.0064 | 0.0041 | 0.0046 | 0.009 | 0.0107 | 0.0111 | 0.0031 | 0.0042 | 0.0056 |
| Nucleolus | 0.0003 | 0.0002 | 0.0002 | 0 | 0.0007 | 0 | 0.0002 | 0.0001 | 0.0001 | 0.0001 | 0.0002 | 0.0001 | 0.0074 | 0.0005 | 0.0001 | 0 | 0.0002 | 0 |
| Nucleus | 0.0027 | 0.0022 | 0.0022 | 0.0022 | 0.0201 | 0.0015 | 0.0024 | 0.0019 | 0.0018 | 0.002 | 0.0016 | 0.0019 | 0.0091 | 0.0054 | 0.0016 | 0.0009 | 0.0031 | 0.0019 |
| Peroxisomes | 0.0017 | 0 | 0.0018 | 0 | 0.0003 | 0.0002 | 0.012 | 0.0001 | 0.0054 | 0.0001 | 0.0058 | 0.0006 | 0.001 | 0.0002 | 0.0072 | 0 | 0.0018 | 0 |
| Punctate Nuclear | 0.0017 | 0.0004 | 0.001 | 0.0003 | 0.0088 | 0.0004 | 0.0017 | 0.0006 | 0.0008 | 0.0007 | 0.0039 | 0.0006 | 0.0014 | 0.001 | 0.0009 | 0.0002 | 0.0008 | 0.0002 |
| Vacuole | 0.063 | 0.0589 | 0.0181 | 0.0135 | 0.0291 | 0.0166 | 0.0134 | 0.0169 | 0.012 | 0.039 | 0.0117 | 0.0133 | 0.0169 | 0.0374 | 0.0245 | 0.0055 | 0.0263 | 0.013 |
| Vacuole Periphery | 0.0022 | 0.0009 | 0.002 | 0.0003 | 0.0018 | 0.0006 | 0.0016 | 0.0006 | 0.0006 | 0.0023 | 0.0006 | 0.0005 | 0.0035 | 0.0028 | 0.0008 | 0.0007 | 0.0033 | 0.0006 |
Sequencing Data
| R1 | R2 | |||||||||
|---|---|---|---|---|---|---|---|---|---|---|
| G1 Post-START | S/G2 | Metaphase | Anaphase | Telophase | G1 Post-START | S/G2 | Metaphase | Anaphase | Telophase | |
| Gene Expression | 582.111 | 209.0548 | 81.1659 | 192.213 | 390.0389 | 429.1054 | 127.6103 | 72.2153 | 150.8985 | 453.5565 |
| Translational Efficiency | 1.3991 | 1.2262 | 1.1044 | 1.0861 | 1.3568 | 2.0305 | 1.4299 | 1.2085 | 1.4758 | 1.492 |
Hit Data
| Dataset | Hit |
|---|---|
| Protein Concentration | ✘ |
| Protein Localization | ✔ |
| Gene Expression | ✔ |
| Translational Efficiency | ✔ |
Endocytosis
| Temp | Actin Patch (Sac6-tdTomato) | Cortical Patch (Sla1-GFP) | Late Endosome (Snf7-GFP) | Vacuole (Vph1-GFP) |
|---|---|---|---|---|
| 37℃ | ||||
| RT |
Cell Cycle Omics
CYCLoPs (Crh1-GFP)
| Gene / Allele | Actin Patch (Sac6-tdTomato) | Cortical Patch (Sla1-GFP) | Late Endosome (Snf7-GFP) | Vacuole (Sac6-tdTomato) |
|---|
| Gene | Images |
|---|
| Gene | Images |
|---|
Images are not yet available
Images are not yet available